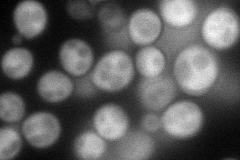
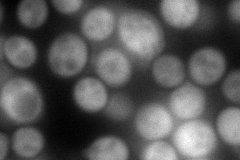
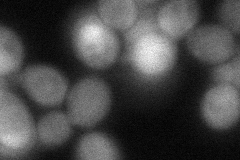
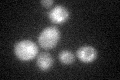

View description
Alanine:glyoxylate aminotransferase (AGT), catalyzes the synthesis of glycine from glyoxylate, which is one of three pathways for glycine biosynthesis in yeast; has similarity to mammalian and plant alanine:glyoxylate aminotransferases
Localization:
Intensity:
Fold change:
Significance:
-
C’ GFP library in SD

below threshold17.28 -
N' NOP1pr-GFP in SD
cytosol111.916 -
N' TEF2pr-mCherry in SD
cytosol215.266 -
N' NATIVEpr-GFP in SD

below threshold18.4907 -
N' TEF2pr-VC and Cyto-VN in SD
cytosol62.0461 -
C’ GFP library in SD+DTT
cytosol17.120.99No -
C’ GFP library in SD+H2O2

cytosol21.541.24No -
C’ GFP library in Starvation Media

cytosol35.862.07No -
C’ GFP library on the background of Pup2-DaMP

below threshold -
C’ GFP library on the background of CCT mutant

below threshold19.78881.14493No
